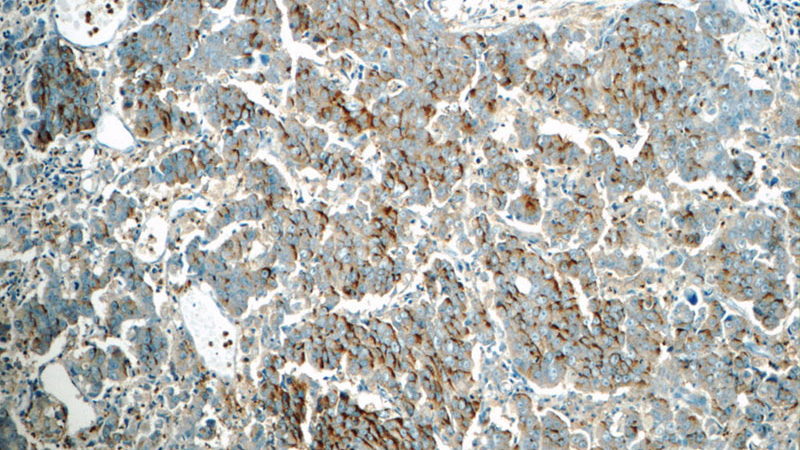
Immunohistochemistry of paraffin-embedded human prostate cancer tissue slide using Catalog No:114444(RAB3D Antibody) at dilution of 1:50 (under 10x lens)
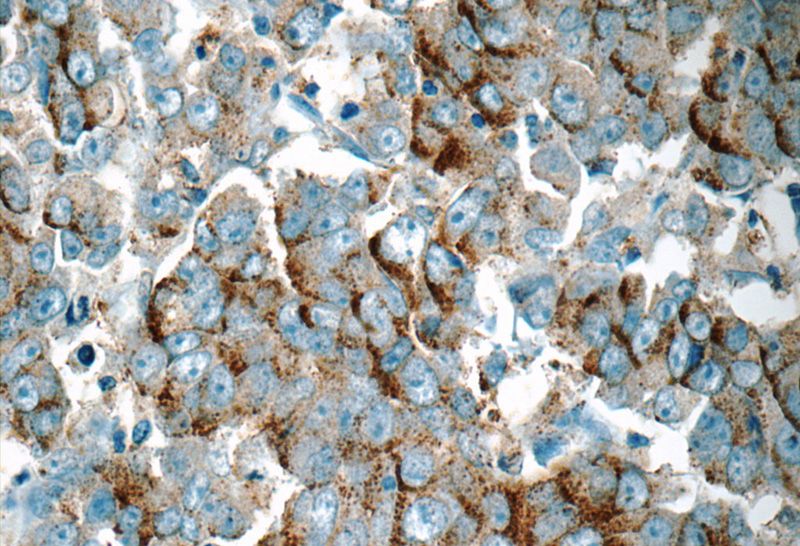
Immunohistochemistry of paraffin-embedded human prostate cancer tissue slide using Catalog No:114444(RAB3D Antibody) at dilution of 1:50 (under 40x lens)

-
Product Name
RAB3D antibody
- Documents
-
Description
RAB3D Rabbit Polyclonal antibody. Positive IHC detected in human prostate cancer tissue, human breast cancer tissue. Positive IP detected in SW 1990 cells. Positive WB detected in mouse lung tissue, A549 cells, human cerebellum tissue, human stomach tissue, mouse spleen tissue, mouse stomach tissue, SW 1990 cells. Observed molecular weight by Western-blot: 28 kDa
-
Tested applications
ELISA, IHC, IP, WB
-
Species reactivity
Human,Mouse,Rat; other species not tested.
-
Alternative names
D2 2 antibody; GOV antibody; RAB16 antibody; RAB3D antibody; RAD3D antibody; Ras related protein Rab 3D antibody
- Immunogen
-
Isotype
Rabbit IgG
-
Preparation
This antibody was obtained by immunization of RAB3D recombinant protein (Accession Number: NM_004283). Purification method: Antigen affinity purified.
-
Clonality
Polyclonal
-
Formulation
PBS with 0.1% sodium azide and 50% glycerol pH 7.3.
-
Storage instructions
Store at -20℃. DO NOT ALIQUOT
-
Applications
Recommended Dilution:
WB: 1:500-1:5000
IP: 1:200-1:2000
IHC: 1:20-1:200
-
Validations

IP Result of anti-RAB3D (IP:Catalog No:114444, 3ug; Detection:Catalog No:114444 1:600) with SW 1990 cells lysate 2400ug.
Immunohistochemistry of paraffin-embedded human prostate cancer tissue slide using Catalog No:114444(RAB3D Antibody) at dilution of 1:50 (under 10x lens)
Immunohistochemistry of paraffin-embedded human prostate cancer tissue slide using Catalog No:114444(RAB3D Antibody) at dilution of 1:50 (under 40x lens)

mouse lung tissue were subjected to SDS PAGE followed by western blot with Catalog No:114444(RAB3D Antibody) at dilution of 1:1200
-
Background
Rab3D is a member of the Rab3 subfamily, which comprises four isoforms (Rab3A, Rab3B, Rab3C, and Rab3D). Rab3 proteins typically associate with secretory vesicles, including synaptic vesicles, and have been implicated in the control of regulated exocytosis. Rab3D is widely expressed in adipocytes, exocrine glands and several haematopoietic cells, where it localizes to secretory granules and vesicles.
-
References
- Ishikawa T, Takizawa T, Iwaki J. Fc gamma receptor IIb participates in maternal IgG trafficking of human placental endothelial cells. International journal of molecular medicine. 35(5):1273-89. 2015.
- Fukui K, Yasui T, Gomi H. Histochemical distribution of sialic acids and antimicrobial substances in porcine carpal glands. Archives of dermatological research. 304(8):599-607. 2012.
- Fukui K, Yasui T, Gomi H. Histochemical localization of sialic acids and antimicrobial substances in eccrine glands of porcine snout skin. European journal of histochemistry : EJH. 56(1):e6. 2012.
- Kamoi M, Ogawa Y, Nakamura S. Accumulation of secretory vesicles in the lacrimal gland epithelia is related to non-Sjögren's type dry eye in visual display terminal users. PloS one. 7(9):e43688. 2012.
- Weis VG, Petersen CP, Mills JC, Tuma PL, Whitehead RH, Goldenring JR. Establishment of novel in vitro mouse chief cell and SPEM cultures identifies MAL2 as a marker of metaplasia in the stomach. American journal of physiology. Gastrointestinal and liver physiology. 307(8):G777-92. 2014.
Related Products / Services
Please note: All products are "FOR RESEARCH USE ONLY AND ARE NOT INTENDED FOR DIAGNOSTIC OR THERAPEUTIC USE"
